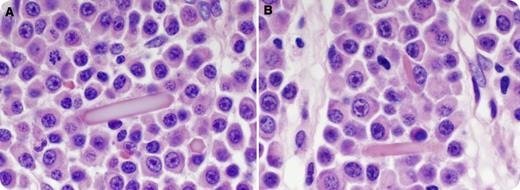
A 68-year-old man presented with pain and malaise. Laboratory studies showed pancytopenia, hypercalcemia, increased creatinine, and proteinuria. Serum protein electrophoresis revealed an M-spike (0.2 g/dL) and immunofixation confirmed λ-light chain. Bone marrow showed sheets of λ-light chain restricted plasma cells with readily identifiable extracellular hexagonal crystals on aspirate and biopsy (panel A), and occasional intracellular crystals in plasma cells on biopsy (panel B). The crystals were eosinophilic by hematoxylin and eosin stain. They failed to stain for Wright-Giemsa or κ-/λ-light chains. No giant cell reaction was observed. / Russell and Dutcher bodies are cytoplasmic and pseudonuclear globular immunoglobulin inclusions and can be seen in plasma cell myeloma (PCM). Extracellular and intracellular crystal deposition, however, is a rare but documented finding in PCM. Indirect immunoperoxidase method reportedly disclosed their immunoglobulin nature. Lack of immunostain for light chains has been a consistent finding and likely attributable to the crystalline conformation. Electron microscopy demonstrated crystalline structures surrounded by smooth membrane. Associated M-protein can be κ- or λ-light chains or full immunoglobulin, most commonly immunoglobulin G. Giant cell reactions are rare. Crystal deposition at other sites such as joint, kidney, and skin has been reported in PCM. The prognostic significance of crystal deposition in PCM has not been clearly documented.

A 68-year-old man presented with pain and malaise. Laboratory studies showed pancytopenia, hypercalcemia, increased creatinine, and proteinuria. Serum protein electrophoresis revealed an M-spike (0.2 g/dL) and immunofixation confirmed λ-light chain. Bone marrow showed sheets of λ-light chain restricted plasma cells with readily identifiable extracellular hexagonal crystals on aspirate and biopsy (panel A), and occasional intracellular crystals in plasma cells on biopsy (panel B). The crystals were eosinophilic by hematoxylin and eosin stain. They failed to stain for Wright-Giemsa or κ-/λ-light chains. No giant cell reaction was observed.
Russell and Dutcher bodies are cytoplasmic and pseudonuclear globular immunoglobulin inclusions and can be seen in plasma cell myeloma (PCM). Extracellular and intracellular crystal deposition, however, is a rare but documented finding in PCM. Indirect immunoperoxidase method reportedly disclosed their immunoglobulin nature. Lack of immunostain for light chains has been a consistent finding and likely attributable to the crystalline conformation. Electron microscopy demonstrated crystalline structures surrounded by smooth membrane. Associated M-protein can be κ- or λ-light chains or full immunoglobulin, most commonly immunoglobulin G. Giant cell reactions are rare. Crystal deposition at other sites such as joint, kidney, and skin has been reported in PCM. The prognostic significance of crystal deposition in PCM has not been clearly documented.
A 68-year-old man presented with pain and malaise. Laboratory studies showed pancytopenia, hypercalcemia, increased creatinine, and proteinuria. Serum protein electrophoresis revealed an M-spike (0.2 g/dL) and immunofixation confirmed λ-light chain. Bone marrow showed sheets of λ-light chain restricted plasma cells with readily identifiable extracellular hexagonal crystals on aspirate and biopsy (panel A), and occasional intracellular crystals in plasma cells on biopsy (panel B). The crystals were eosinophilic by hematoxylin and eosin stain. They failed to stain for Wright-Giemsa or κ-/λ-light chains. No giant cell reaction was observed.
Russell and Dutcher bodies are cytoplasmic and pseudonuclear globular immunoglobulin inclusions and can be seen in plasma cell myeloma (PCM). Extracellular and intracellular crystal deposition, however, is a rare but documented finding in PCM. Indirect immunoperoxidase method reportedly disclosed their immunoglobulin nature. Lack of immunostain for light chains has been a consistent finding and likely attributable to the crystalline conformation. Electron microscopy demonstrated crystalline structures surrounded by smooth membrane. Associated M-protein can be κ- or λ-light chains or full immunoglobulin, most commonly immunoglobulin G. Giant cell reactions are rare. Crystal deposition at other sites such as joint, kidney, and skin has been reported in PCM. The prognostic significance of crystal deposition in PCM has not been clearly documented.
For additional images, visit the ASH IMAGE BANK, a reference and teaching tool that is continually updated with new atlas and case study images. For more information visit http://imagebank.hematology.org.